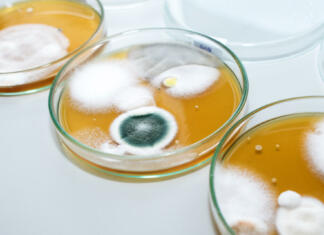
Na teh javnih mestih se nabere največ bakterij… Molds colonies culture in petri dishes with mea malt extract agar. Fungus growth in plate of Medical tests or Laboratory experiment.

Timotej Prosenc
Nezaželeni »sosedje«! To so škodljivci, ki lahko živijo v vaši postelji
Postelja, kraj udobja in počitka, včasih postane tudi dom nezaželenim gostom - škodljivcem, ki lahko predstavljajo resno tveganje za vaše zdravje in dobro počutje....
Odgovarjamo na večno vprašanje: prati na roke ali strojno?
Vprašanje o tem, ali je bolje pomivati posodo na roke ali uporabiti pomivalni stroj, je pogosto predmet razprav med okoliško zavednimi posamezniki. Medtem ko...
Je internet na Marsu mogoč?
Ko bodo astronavti čez nekaj desetletji pristali na Marsu, bodo potrebovali način za medsebojno komunikacijo in z ekipo na Zemlji. Kljub dejstvu, da bodo...
Neandertalski geni vplivajo na to človeško lastnost…
Najnovejše raziskave kažejo, da naj bi ljudje, ki radi vstajajo zgodaj podedovali genetske variante od neandertalcev. Neandertalski DNA naj bi povečal možnosti, da so...
Ekološki ukrepi, ki povzročajo več škode kot koristi
Definicija okolju prijaznega je "neškodljivo za okolje." Vendar pa obstajata dva osnovna problema s to idejo. Prvič, zgolj izogibanje škodi ni dovolj za trajnost...
5 kreativnih načinov za recikliranje stvari kar doma
Trajnostno življenje je postalo vse pomembnejše in eden izmed načinov, kako lahko prispevamo k boljšemu okolju, je recikliranje. Namesto, da bi zavrgli stare predmete,...
Na teh javnih mestih se nabere največ bakterij…
Smo v tistem času leta, ko nam razna obolenja ne prizanašajo. Nenadna ohladitev je na preizkušnjo postavila imunski sistem slehernega posameznika. Ker vem, da...
Ali vetrne elektrarne resnično pobijejo toliko ptic?
Vetrne turbine že dolgo privabljajo pozornost zaradi trkov ptic s vrtečimi se lopaticami ali visokimi stolpi. Večina podatkov o smrti ptic na vetrnih objektih...
Robot, ki bo ljudem ponovno pomagal shoditi…
V zadnjih letih so na področju robotike predstavili vse bolj napredne sisteme, ki bi lahko odprli vznemirljive nove možnosti v kirurgiji, rehabilitaciji in oskrbi...
Nakupovalne navade lahko predvidijo vzrok smrti
Raziskava iz poslovne šole Univerze v Nottinghamu je korak bliže napovedovanju smrti zaradi bolezni dihal s pomočjo analize nakupovalnih navad strank v lokalnih upravnih...